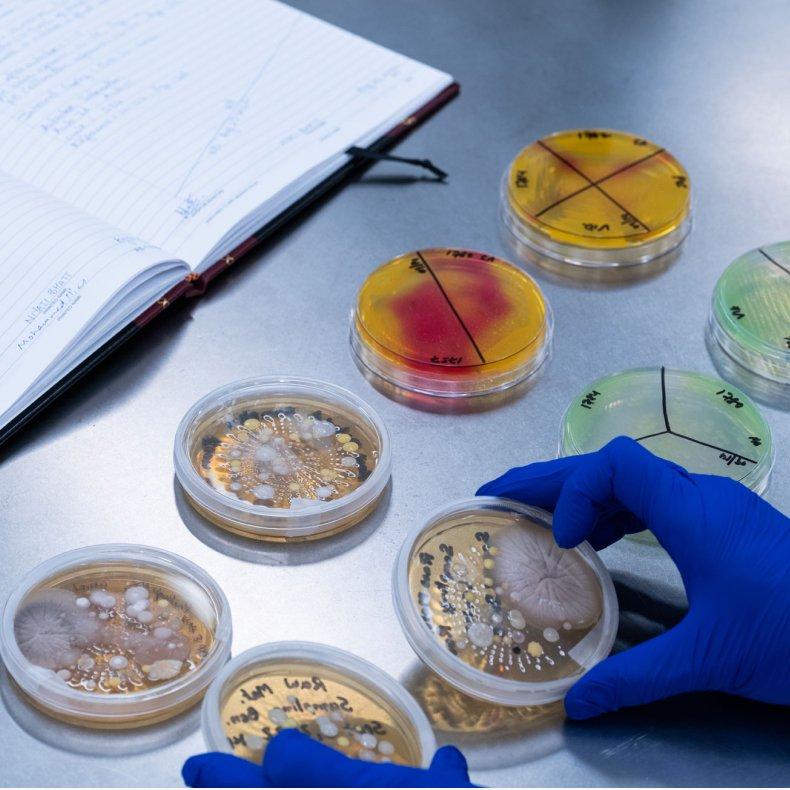
The Ordinary Why does skincare need preservatives?

Have you ever thought about the unseen microbes that hitch a ride on your lip balm each time you use it? Despite this, the balm consistently delivers its intended benefits and lustrous feel. The secret lies in the preservative system present in the formulation, which is a key defence against microbial growth.
Why Does Skincare Need Preservatives?
By: Charu Kothari, a Microbiology Analyst II -R&D at DECIEM, holds a Ph.D. in Molecular Medicine from Université Laval, Canada. She also earned an M.Sc. in Biochemistry and a B.Sc. in Industrial Microbiology from Patna University, India.
Why Contamination is a Cosmetic Catastrophe
Cosmetics are rich in nutrients— which can consist of water or base (eg. oil) and a mix of organic (compound that contains carbon) and inorganic (compounds that do not contain carbon or non-living matter) ingredients. While this makes them beneficial to the skin, it also creates a perfect breeding ground for microorganisms. This vulnerability is amplified by potential contamination at every stage of a product's journey, from the sourcing of raw materials to post-purchase consumer use.
"Microorganisms are ubiquitous—some are harmless, some beneficial, but others can cause disease. Since we cannot control which ones might infiltrate a product, preservatives are crucial to halt microbial growth, ensuring skincare products remain both safe and stable," explains Jatinder Kaur, Head of Microbiology at DECIEM Inc.
Preservatives, naturally-derived or synthetic, are added to food, pharmaceutical, or cosmetic products to safely prevent microbial growth.
How do we protect cosmetics
There are two kinds of preservation strategies - Primary and secondary.
Primary Preservation: Emphasis on good manufacturing practices (GMP). GMP is the backbone of safe cosmetics. They include steps like checking raw materials for microbial impurities, purifying water, and cleaning equipment. ISO 22716 is the global standard followed by cosmetic companies to abide by GMP.
Secondary Preservation: Secondary preservation helps keep a product safe after it’s made, during storage and use. It can be divided into three parts described below:
Physical: Uses primary packaging as a barrier, for example, airless pumps are more effective than wide-mouthed jars at keeping contaminants out.
Physicochemical: Helps maintain the sterility of the product by limiting available water in the product and adjusting its pH. Formulas with a very low (below 4) or very high (above 10) pH can prevent microbes from growing.
Chemical (Synthetic and Naturally-derived): The most common method of preservation is adding synthetic preservatives (like parabens, isothiazolinones, organic acids, and formaldehyde releasers) or naturally-derived ones (such as plant extracts and essential oils). In addition, multifunctional ingredients like chelating agents, surfactants, and humectants can also contribute to preservation.

Preservative choices and dilemma
The Traditional Preservative
For decades, chemical preservatives have been the backbone of cosmetic formulation. However, they come under scrutiny for potential toxicity, allergic reactions and microbial resistance if used in sub-therapeutic concentration. Some of the preservatives also have broad-spectrum efficacy, meaning the same preservative is effective against bacteria, yeast and mold.
Examples of common chemical preservatives:
Parabens: Safe at low concentrations, they disrupt bacterial cell membranes and inhibit enzymes.
Phenoxyethanol: A gentle, effective, broad-spectrum preservative stable across a wide pH range.
Formaldehyde Releasers: Highly regulated, these release small amounts of formaldehyde, a powerful antimicrobial, permitted only in products at very low concentrations. DMDM Hydantoin, Quaternium-15 are some examples of this kind of preservative.
Chlorphenesin: This synthetic organic chemical offers effective antifungal and antibacterial properties, often combined with other preservatives for enhanced efficacy.
The “Natural” Preservative Alternative
The definition of "natural" can be contentious, but we will be defining natural as all preservatives that can be derived from nature without needing to undergo additional chemical processing that alters their structure. These can be organic acids or plant extracts, which have become very popular for their "clean" image and antioxidant properties. These preservatives can often meet challenges due to inconsistent effectiveness, pH and temperature sensitivity, and characteristic odour. However, innovative formulations continue to enhance stability and antimicrobial properties of the natural preservative, making them a viable choice for the mainstream industry.
Examples of “natural” preservatives:
Organic Acids and Salts: Benzoic acid and sodium benzoate, found in plants, combat molds and yeasts in acidic conditions.
Plant Extracts and Essential Oils: Rosemary, thyme, and tea tree oil contain natural antimicrobial compounds.
Fermentation Products: Ingredients like Leucidal Liquid SF MAX are created by controlling the fermentation process of Lactobacilli, in order for it to produce antimicrobial agents known as bacteriocins.

The nature-identical preservative:
Some preservatives, though available synthetically, were originally derived from plants or are nature identical. Some examples are benzoic acid, sodium benzoate (sodium salt of benzoic acid), potassium sorbate (potassium, salt of sorbic acid), benzyl alcohol (present in many plants and essential oils), caprylyl glycol (found in consul and palm oil), and phenoxyethanol (small amount in green tea).
Beyond the Binary: The Future of Preservation
Modern cosmetic preservation relies on a combination of systems that reduce the need for high concentrations of traditional chemicals. This includes using multifunctional ingredients like caprylyl glycol and ethylhexylglycerin, which act as both skincare actives and preservation boosters to enhance product safety and efficacy. Formulators also manipulate the product environment through low water activity and non-physiological pH, and leverage technological advancements such as airless pumps and ultra-high temperature sterilization. Ultimately, selecting the right preservation strategy is a complex decision balanced by scientific requirements, consumer preferences, and regulatory standards.

How do we ensure that the preservatives are working:
Cosmetic products are complex. While simple water-based solutions exist, you will also come across gels, or emulsions‒smooth, even mixtures of things that usually don't mix, like water and oil. Preservatives work best when they're evenly spread throughout the product, meaning throughout its various phases. If the preservative is only available in one part of the product (for example, if it's only mixing with the oil, but not water) then microorganisms can exploit the unpreserved part as safe haven for growth, causing the product to spoil.
As Jatinder Kaur, Head of Microbiology at DECIEM Inc, explains: “A preservative’s effectiveness isn’t just about the total amount you add; it’s about its availability to fight microorganisms. Sometimes, other cosmetic ingredients can actually enhance this availability, while others may interfere. That’s why two formulas with the exact same preservative level can perform very differently.”
Preservative/Antimicrobial effectiveness testing (PET/AET):
Antimicrobial effectiveness testing (AET) is a safety check for pharmaceuticals, cosmetics, and personal care products. It confirms that preservatives are strong enough to stop harmful microorganisms from growing during the product’s shelf life.
In this test, microbes such as Staphylococcus aureus, Escherichia coli, Pseudomonas aeruginosa, Candida albicans, and Aspergillus brasiliensis are deliberately added to products. . Over several weeks, scientists measure the decrease in the microbial population. To meet quality standards, preservatives in products must show a significant reduction in bacteria (99.9%) and yeast and mold (90%).
In addition to microbiological testing, chemical analysis is also conducted to ensure preservatives are stable, have not degraded, and are present at the correct concentration throughout the product, including in different phases for emulsions. Together, these tests confirm both the effectiveness and long-term stability of a product’s preservative system.
Keep It Fresh, Keep It Safe— Thanks to Preservatives!

Modern preservation is about smart, science-driven strategies. Effective preservation is essential for safe, stable, and high-quality cosmetics. By combining good manufacturing practices, smart formulation, and appropriate preservatives, brands ensure their products remain effective, hygienic, and enjoyable for consumers, while meeting regulatory standards.
Final words
Tonight, as you enjoy your favorite skincare, remember its unsung heroes: the preservatives. They ensure your product is safe and effective until the very last drop.

